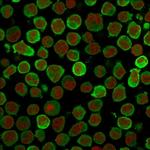
Calponin-1 (Smooth Muscle Marker) Antibody in Immunocytochemistry (ICC/IF)

Search
NeoBiotechnologies
Calponin-1 (Smooth Muscle Marker) Monoclonal Antibody (CALP)
{{$productOrderCtrl.translations['antibody.pdp.commerceCard.promotion.promotions']}}
{{$productOrderCtrl.translations['antibody.pdp.commerceCard.promotion.viewpromo']}}
{{$productOrderCtrl.translations['antibody.pdp.commerceCard.promotion.promocode']}}: {{promo.promoCode}} {{promo.promoTitle}} {{promo.promoDescription}}. {{$productOrderCtrl.translations['antibody.pdp.commerceCard.promotion.learnmore']}}
产品信息
1264-MSM1-P0
种属反应
宿主/亚型
分类
类型
克隆号
抗原
偶联物
形式
浓度
规格
纯化类型
保存液
内含物
保存条件
运输条件
靶标信息
Calponin, a thin filament associated protein is implicated in the regulation and modulation of smooth muscle contraction. It is capable of binding to actin, calmodulin, troponin C and tropomyosin. Calponin is expressed in smooth muscle and tissues containing significant amounts of smooth muscle. Two isoforms of calponin exist whose molecular weights are 34kDa and 29kDa. Expression of the 29kDa form is primarily restricted to muscle of the urogenital tract. The expression of calponin has also been demonstrated in myoepithelial cells from benign and malignant breast lesions. It stains smooth muscle, myoepithelial cells, myofibroblasts, keratinocytes and nerve fibers. It identifies myoepithelial cells in breast lesions, and helps differentiate breast collagenous spherulosis (positive) from adenoid cystic carcinoma. Adenoid cystic carcinoma in salivary gland tumors is calponin positive.
仅用于科研。不用于诊断过程。未经明确授权不得转售。
篇参考文献 (0)
生物信息学
蛋白别名: Basic calponin; calponin 1, basic, smooth muscle; calponin 1, smooth muscle; Calponin H1, smooth muscle; Calponin-1; calponins, basic; epididymis secretory protein Li 14; unnamed protein product
基因别名: CNN1; HEL-S-14; Sm-Calp; SMCC
UniProt ID: (Human) P51911, (Rat) Q08290
Entrez Gene ID: (Human) 1264, (Rat) 65204